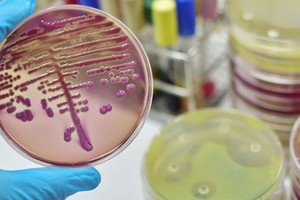
Se trataba de una bacteria "pan-drogo resistente". Créditos: Télam

La resistencia a los antibióticos es una de las amenazas a la salud mundial. En la búsqueda de soluciones, un equipo ha identificado, con la ayuda de inteligencia artificial, casi un millón de fuentes potenciales de antibióticos en la naturaleza.
Gracias a la Inteligencia Artificial, hallaron casi un millón de posibles antibióticos naturales
Investigadores encontraron péptidos antimicrobianos que podrían ser la clave para combatir la resistencia bacteriana.

Una investigación que publica Cell extrajo datos genómicos en busca de nuevos antibióticos en el microbioma mundial e identificó 863.498 péptidos antimicrobianos prometedores, pequeñas moléculas que pueden matar o inhibir el crecimiento de microbios infecciosos. El 90 % nunca se había descrito antes.
La resistencia a los antimicrobianos es una de las "principales amenazas para la salud pública, ya que mata a 1,27 millones de personas cada año", destacó el investigador Luis Pedro Coelho, de la Universidad Tecnológica de Queensland (Australia) y uno de los firmantes del artículo.
Sin ninguna intervención se calcula que la resistencia a los antimicrobianos podría causar hasta diez millones de muertes en el año 2050, por lo que hay "una necesidad urgente de nuevos métodos para descubrir antibióticos", agregó.
Inteligencia artificial: posibles compuestos antibióticos
Los investigadores usaron el aprendizaje automático para analizar más de 60.000 metagenomas (una colección de genomas dentro de un entorno específico) que, en conjunto, contenían la composición genética de más de un millón de organismos. Procedían de fuentes de todo el mundo, incluidos entornos marinos y del suelo, e intestinos humanos y animales.
El resultado fue de casi un millón de posibles compuestos antibióticos, de los que docenas mostraban una actividad prometedora en las pruebas iniciales contra bacterias causantes de enfermedades.

El equipo verificó las predicciones probando 100 péptidos fabricados en laboratorio contra patógenos clínicamente significativos.
Descubrieron que 79 alteraban las membranas bacterianas y 63 atacaban específicamente bacterias resistentes a los antibióticos, como Staphylococcus aureus y Escherichia coli.
En algunos casos esas moléculas eran eficaces contra las bacterias a dosis muy bajas, resaltó otro de los firmantes César de la Fuente, de la Universidad de Pensilvania (EE. UU.).
Modelo probado en ratones
En un modelo preclínico, probado en ratones infectados, el tratamiento con esos péptidos produjo resultados similares a los efectos de la polimixina B, un antibiótico comercial que se utiliza para tratar la meningitis, la neumonía, la sepsis y las infecciones del tracto urinario, según un comunicado.
Los compuestos identificados procedían de microbios que vivían en una gran variedad de hábitats, como la saliva humana, las vísceras de cerdo, el suelo y las plantas, los corales y muchos otros organismos terrestres y marinos. Esto valida el amplio enfoque de los investigadores para explorar los datos biológicos del mundo.
La naturaleza siempre ha sido un buen lugar para buscar nuevos medicamentos, especialmente antibióticos. Las bacterias, omnipresentes en nuestro planeta, han desarrollado numerosas defensas antibacterianas, a menudo en forma de proteínas cortas ("péptidos") que pueden alterar las membranas celulares bacterianas y otras estructuras críticas.
Además, la inteligencia artificial en el descubrimiento de antibióticos "es ya una realidad y ha acelerado significativamente nuestra capacidad para descubrir nuevos fármacos candidatos. Lo que antes llevaba años ahora se puede conseguir en horas utilizando ordenadores", afirmó De la Fuente.

Dejanos tu comentario
Los comentarios realizados son de exclusiva responsabilidad de sus autores y las consecuencias derivadas de ellos pueden ser pasibles de las sanciones legales que correspondan. Evitar comentarios ofensivos o que no respondan al tema abordado en la información.